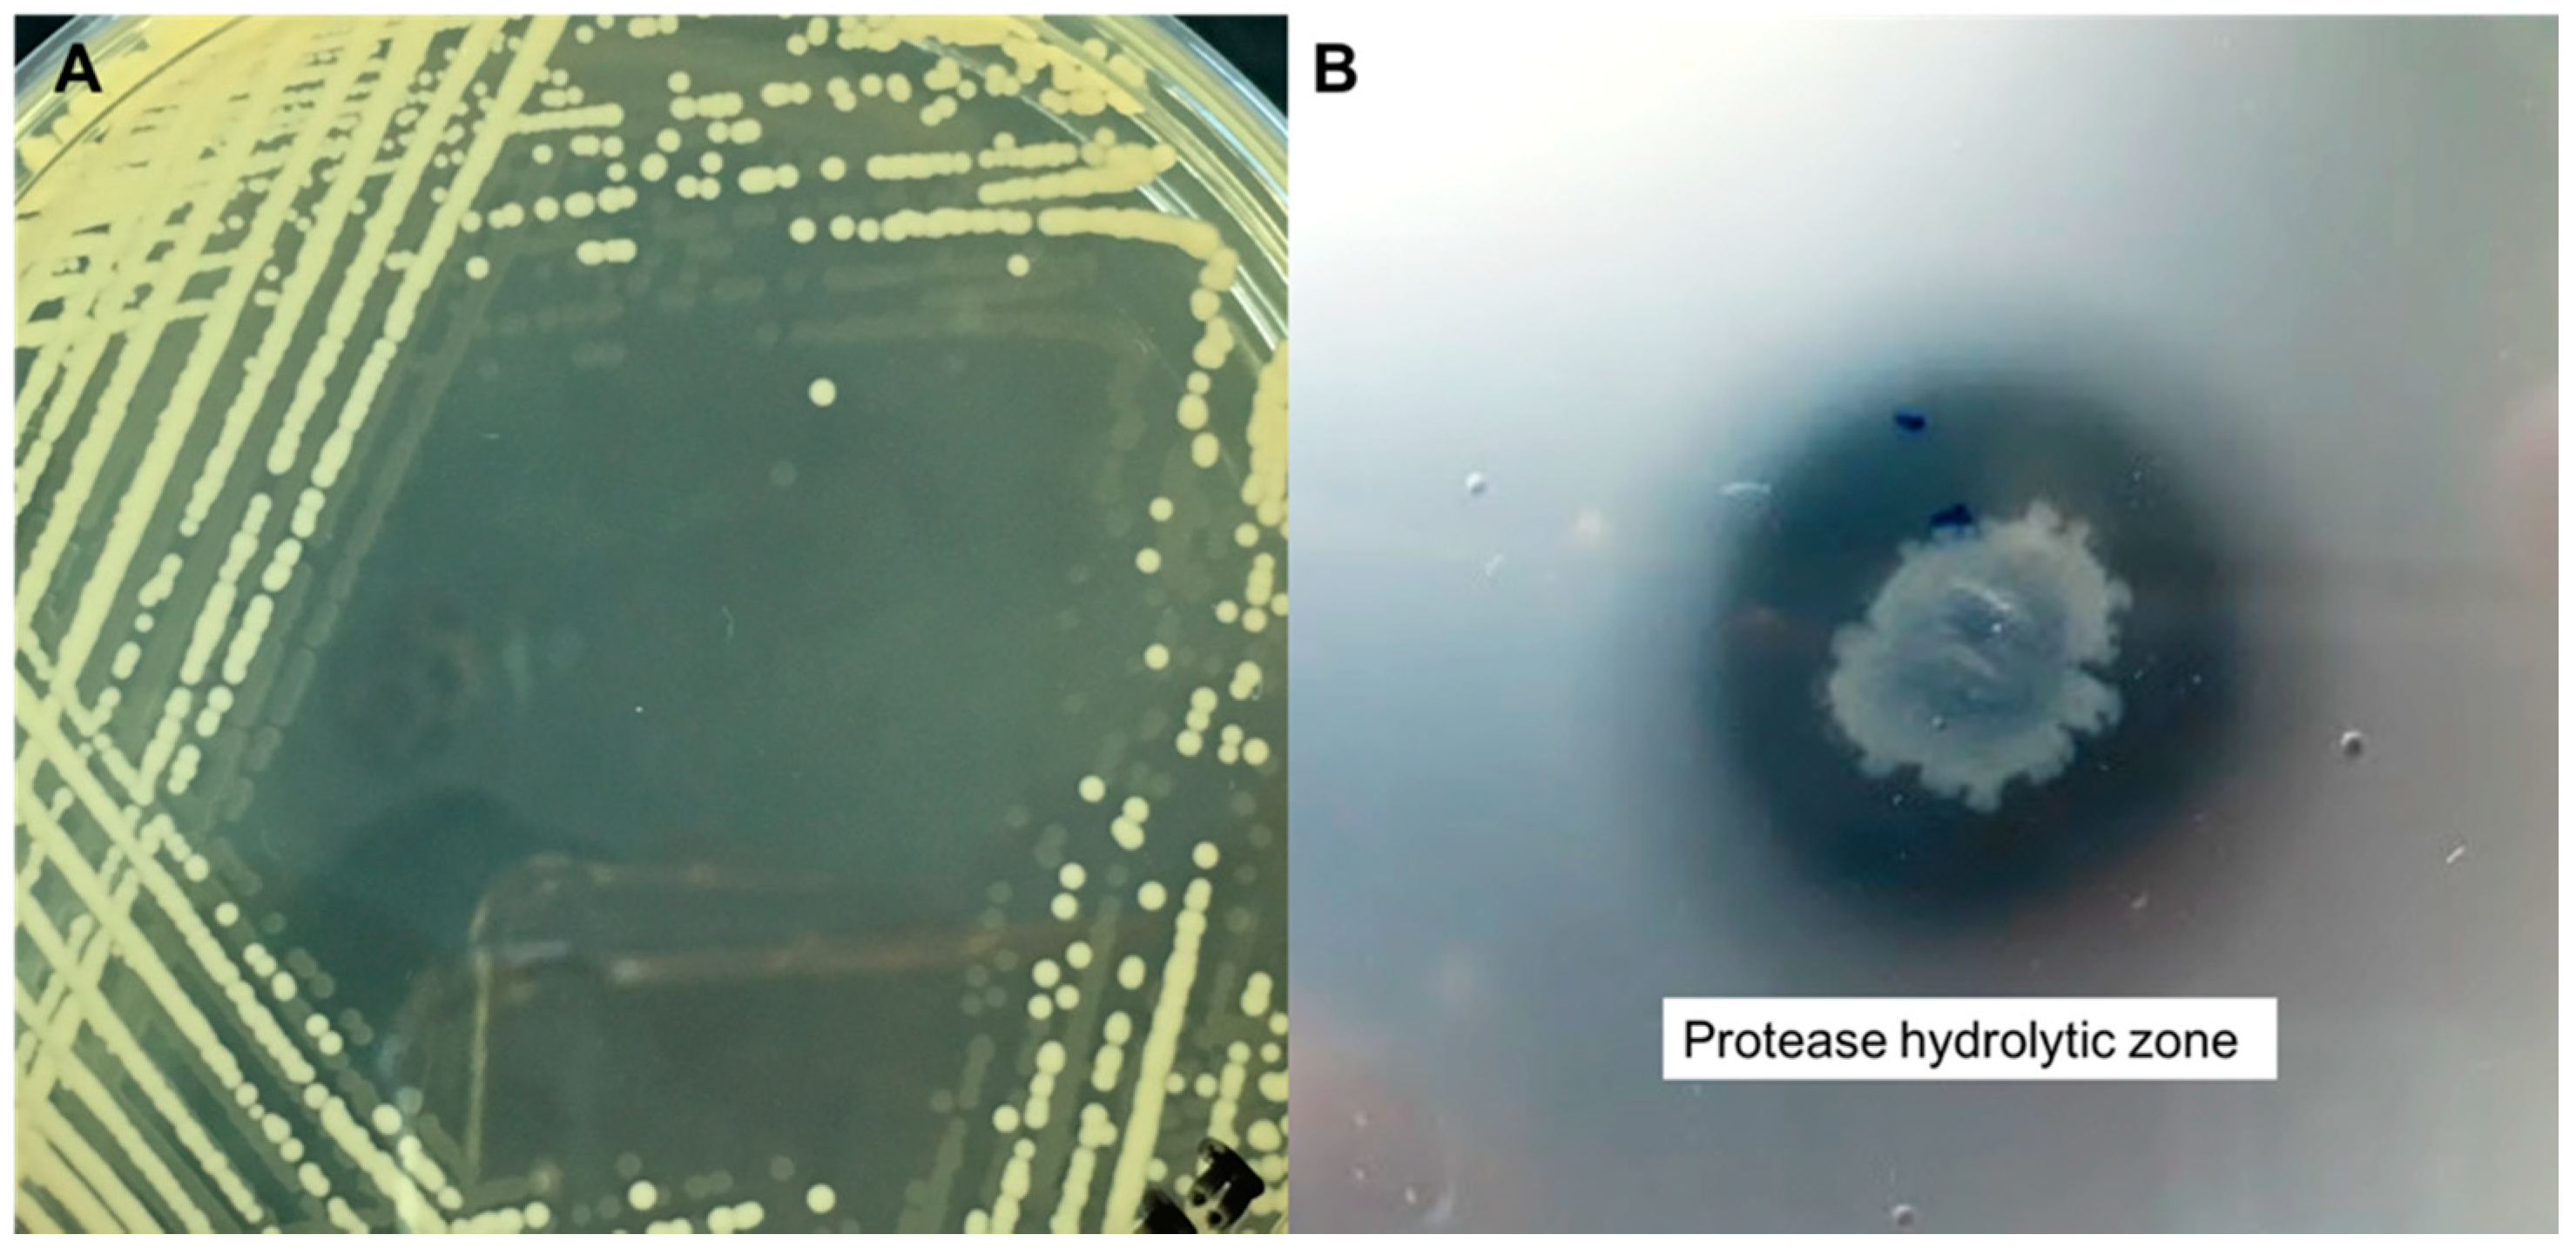

Effect of Cultural Conditions on Protease Production by a Thermophilic Geobacillus thermoglucosidasius SKF4 Isolated from Sungai Klah Hot Spring Park, Malaysia
Abstract
1. Introduction
2. Materials and Methods
2.1. Sample Collection
2.2. Qualitative Screening of Protease Activity
2.3. Protease Activity Assay
2.4. Morphology of the Colonies
2.5. Molecular Identification of Isolate SKF4
2.6. Effects of Cultural Conditions on Bacterial Growth and Protease Production of Isolate SKF4
2.6.1. Effects of Temperature
2.6.2. Effects of Carbon Sources
2.6.3. Effects of pH
2.6.4. Effects of Nitrogen Sources
2.6.5. Effects of Incubation Time
3. Results and Discussion
3.1. Isolation and Identification of Isolate SKF4
3.2. Effects of Different Parameters on the Growth and Protease Production of G. thermoglucosidasius SKF4
3.2.1. Effects of Temperature
3.2.2. Effects of pH
3.2.3. Effects of the Carbon Source
3.2.4. Effects of NaCl Concentration
3.2.5. Effects of Nitrogen Sources
3.2.6. Effects of Incubation Time
4. Conclusions
Author Contributions
Funding
Acknowledgments
Conflicts of Interest
References
- Ibrahim, A.S.S.; Al-Salamah, A.A.; Elbadawi, Y.B.; El-Tayeb, M.A.; Ibrahim, S.S.S. Production of extracellular alkaline protease by new halotolerant alkaliphilic Bacillus sp. NPST-AK15 isolated from hyper saline soda lakes. Electron. J. Biotechnol. 2015, 18, 236–243. [Google Scholar] [CrossRef]
- Yildirim, V.; Baltaci, M.O.; Ozgencli, I.; Sisecioglu, M.; Adiguzel, A.; Adiguzel, G. Purification and biochemical characterization of a novel thermostable serine alkaline protease from Aeribacillus pallidus C10: A potential additive for detergents. J. Enzym. Inhib. Med. Chem. 2017, 32, 468–477. [Google Scholar] [CrossRef] [PubMed]
- Rao, M.B.; Tanksale, A.M.; Ghatge, M.S.; Deshpande, V.V. Molecular and biotechnological aspects of microbial proteases. Microbiol. Mol. Biol. Rev. 1998, 62, 597–635. [Google Scholar] [CrossRef] [PubMed]
- Mahajan, R.T.; Badgujar, S.B. Biological aspects of proteolytic enzymes: A Review. J. Pharm. Res. 2010. [Google Scholar]
- Subba Rao, C.; Sathish, T.; Ravichandra, P.; Prakasham, R.S. Characterization of thermo- and detergent stable serine protease from isolated Bacillus circulans and evaluation of eco-friendly applications. Process Biochem. 2009, 44, 262–268. [Google Scholar] [CrossRef]
- Baker, G. Bacterial community analysis of Indonesian hot springs. FEMS Microbiol. Lett. 2001, 200, 103–109. [Google Scholar] [CrossRef]
- Bertoldo, C.; Antranikian, G. Starch-hydrolyzing enzymes from thermophilic archaea and bacteria. Curr. Opin. Chem. Biol. 2002, 6, 151–160. [Google Scholar] [CrossRef]
- Nazina, T.N.; Tourova, T.P.; Poltaraus, A.B.; Novikova, E.V.; Grigoryan, A.A.; Ivanova, A.E.; Lysenko, A.M.; Petrunyaka, V.V.; Osipov, G.A.; Belyaev, S.S.; et al. Taxonomic study of aerobic thermophilic bacilli: Descriptions of Geobacillus subterraneus gen. nov., sp. nov. and Geobacillus uzenensis sp. nov. from petroleum reservoirs and transfer of Bacillus stearothermophilus, Bacillus thermocatenulatus, Bacillus th. Int. J. Syst. Evol. Microbiol. 2001. [Google Scholar] [CrossRef]
- Meintanis, C.; Chalkou, K.I.; Kormas, K.A.; Karagouni, A.D. Biodegradation of Crude Oil by Thermophilic Bacteria Isolated from a Volcano Island. Biodegradation 2006, 17, 3–9. [Google Scholar] [CrossRef]
- Lama, L.; Calandrelli, V.; Gambacorta, A.; Nicolaus, B. Purification and characterization of thermostable xylanase and β-xylosidase by the thermophilic bacterium Bacillus thermantarcticus. Res. Microbiol. 2004, 155, 283–289. [Google Scholar] [CrossRef]
- Schallmey, M.; Singh, A.; Ward, O.P. Developments in the use of Bacillus species for industrial production. Can. J. Microbiol. 2004, 50, 1–17. [Google Scholar] [CrossRef] [PubMed]
- Brumm, P.J.; Land, M.L.; Mead, D.A. Complete genome sequence of Geobacillus thermoglucosidasius C56-YS93, a novel biomass degrader isolated from obsidian hot spring in Yellowstone National Park. Stand. Genomic Sci. 2015, 10, 73. [Google Scholar] [CrossRef] [PubMed]
- Hawumba, J.F.; Theron, J.; Brözel, V.S. Thermophilic Protease-Producing Geobacillus from Buranga Hot Springs in Western Uganda. Curr. Microbiol. 2002, 45, 144–150. [Google Scholar] [CrossRef] [PubMed]
- Maugeri, T.L.; Gugliandolo, C.; Caccamo, D.; Stackebrandt, E. Three novel halotolerant and thermophilic Geobacillus strains from shallow marine vents. Syst. Appl. Microbiol. 2002, 25, 450–455. [Google Scholar] [CrossRef] [PubMed]
- Zahoor, S.; Javed, M.M.; Babarl, M.E. Characterization Of A Novel Hydrolytic Enzyme Producing Thermophilic Bacterium Isolated From The Hot Spring Of Azad Kashmir-Pakistan. Brazilian Arch. Biol. Technol. 2016, 59. [Google Scholar] [CrossRef]
- Asha, B.; Palaniswamy, M. Optimization of alkaline protease production by Bacillus cereus FT 1 isolated from soil. J. Appl. Pharm. Sci. 2018. [Google Scholar]
- Saxena, A.; Yadav, A.N.; Rajawat, M.; Kaushik, R.; Kumar, R.; Kumar, M.; Prasanna, R.; Shukla, L. Microbial Diversity of Extreme Regions: An Unseen Heritage and Wealth. Indian J. Plant Genet. Resour. 2016, 29, 246. [Google Scholar] [CrossRef]
- Sahay, H.; Yadav, A.N.; Singh, A.K.; Singh, S.; Kaushik, R.; Saxena, A.K. Hot springs of Indian Himalayas: Potential sources of microbial diversity and thermostable hydrolytic enzymes. 3 Biotech 2017, 7, 118. [Google Scholar] [CrossRef]
- Cripps, R.E.; Eley, K.; Leak, D.J.; Rudd, B.; Taylor, M.; Todd, M.; Boakes, S.; Martin, S.; Atkinson, T. Metabolic engineering of Geobacillus thermoglucosidasius for high yield ethanol production. Metab. Eng. 2009, 11, 398–408. [Google Scholar] [CrossRef]
- Lin, P.P.; Rabe, K.S.; Takasumi, J.L.; Kadisch, M.; Arnold, F.H.; Liao, J.C. Isobutanol production at elevated temperatures in thermophilic Geobacillus thermoglucosidasius. Metab. Eng. 2014, 24, 1–8. [Google Scholar] [CrossRef]
- Zeigler, D.R. The Geobacillus paradox: Why is a thermophilic bacterial genus so prevalent on a mesophilic planet? Microbiology 2014, 160, 1–11. [Google Scholar] [CrossRef] [PubMed]
- Cui, H.; Yang, M.; Wang, L.; Xian, C.J. Identification of a New Marine Bacterial Strain SD8 and Optimization of Its Culture Conditions for Producing Alkaline Protease. PLoS ONE 2015, 10, e0146067. [Google Scholar] [CrossRef] [PubMed]
- Akhavan Sepahy, A.; Jabalameli, L. Effect of Culture Conditions on the Production of an Extracellular Protease by Bacillus sp. Isolated from Soil Sample of Lavizan Jungle Park. Enzym. Res. 2011, 2011, 1–7. [Google Scholar]
- Chan, C.S.; Chan, K.-G.; Tay, Y.-L.; Chua, Y.-H.; Goh, K.M. Diversity of thermophiles in a Malaysian hot spring determined using 16S rRNA and shotgun metagenome sequencing. Front. Microbiol. 2015, 6. [Google Scholar] [CrossRef] [PubMed]
- McDonald, C.E.; Chen, L.L. The Lowry modification of the Folin reagent for determination of proteinase activity. Anal. Biochem. 1965, 10, 175–177. [Google Scholar] [CrossRef]
- Buddingh, G.J. Bergey’s Manual of Determinative Bacteriology. Am. J. Trop. Med. Hyg. 1975, 24, 550. [Google Scholar] [CrossRef]
- Waterhouse, A.M.; Procter, J.B.; Martin, D.M.A.; Clamp, M.; Barton, G.J. Jalview Version 2-a multiple sequence alignment editor and analysis workbench. Bioinformatics 2009, 25, 1189–1191. [Google Scholar] [CrossRef]
- Sinha, R.; Khare, S.K. Characterization of detergent compatible protease of a halophilic Bacillus sp. EMB9: Differential role of metal ions in stability and activity. Bioresour. Technol. 2013, 145, 357–361. [Google Scholar] [CrossRef]
- Nazina, T.N. Geobacillus gargensis sp. nov., a novel thermophile from a hot spring, and the reclassification of Bacillus vulcani as Geobacillus vulcani comb. nov. Int. J. Syst. Evol. Microbiol. 2004, 54, 2019–2024. [Google Scholar] [CrossRef]
- Romano, I.; Poli, A.; Lama, L.; Gambacorta, A.; Nicolaus, B. Geobacillus thermoleovorans subsp. stromboliensis subsp. nov., isolated from the geothermal volcanic environment. J. Gen. Appl. Microbiol. 2005, 51, 183–189. [Google Scholar] [CrossRef]
- Obeidat, M.; Khyami-Horani, H.; Al-Zoubi, A. Isolation, characterization, and hydrolytic activities of Geobacillus species from Jordanian hot springs. Afr. J. Biotechnol. 2012, 11. [Google Scholar]
- Cha, M.; Chambliss, G.H. Cloning and sequence analysis of the heat-stable acrylamidase from a newly isolated thermophilic bacterium, Geobacillus thermoglucosidasius AUT-01. Biodegradation 2013. [Google Scholar] [CrossRef]
- Sun, L.; Huang, D.; Zhu, L.; Zhang, B.; Peng, C.; Ma, T.; Deng, X.; Wu, J.; Wang, W. Novel thermostable enzymes from Geobacillus thermoglucosidasius W-2 for high-efficient nitroalkane removal under aerobic and anaerobic conditions. Bioresour. Technol. 2019. [Google Scholar] [CrossRef] [PubMed]
- Espina, G.; Eley, K.; Pompidor, G.; Schneider, T.R.; Crennell, S.J.; Danson, M.J. A novel β-xylosidase structure from Geobacillus thermoglucosidasius: The first crystal structure of a glycoside hydrolase family GH52 enzyme reveals unpredicted similarity to other glycoside hydrolase folds. Acta Crystallogr. Sect. D Biol. Crystallogr. 2014, 70, 1366–1374. [Google Scholar] [CrossRef] [PubMed]
- Szeker, K.; Zhou, X.; Schwab, T.; Casanueva, A.; Cowan, D.; Mikhailopulo, I.A.; Neubauer, P. Comparative investigations on thermostable pyrimidine nucleoside phosphorylases from Geobacillus thermoglucosidasius and Thermus thermophilus. J. Mol. Catal. B Enzym. 2012, 84, 27–34. [Google Scholar] [CrossRef]
- Castagnaro, A. Overexpression and Characterization of a Laccase from Geobacillus thermoglucosidasius; University New Hampshire: Durham, NH, USA, 2014. [Google Scholar]
- Dissanayaka, D.; Rathnayake, I.V.N. Effect of Temperature, pH, Carbon and Nitrogen Sources on Extracellular Protease Production by Four Geobacillus Species Isolated from Maha Oya Geothermal Springs in Sri Lanka. Appl. Microbiol. Open Access 2019, 5, 1–7. [Google Scholar]
- Chen, X.-G.; Stabnikova, O.; Tay, J.-H.; Wang, J.-Y.; Tay, S.T.-L. Thermoactive extracellular proteases of Geobacillus caldoproteolyticus, sp. nov., from sewage sludge. Extremophiles 2004, 8, 489–498. [Google Scholar] [CrossRef]
- Nielsen, J.; Villadsen, J. Bioreaction Engineering Principles; Springer: Boston, MA, USA, 1994; ISBN 978-1-4757-4647-1. [Google Scholar]
- Shanthakumari, A.R.; Boominathan, M. Studies on screening of Bacillus sp. for Protease Production. Int. J. Theor. Appl. Sci. 2017, 9, 294–299. [Google Scholar]
- Ward, O.P.; Moo-Young, M. Thermostable enzymes. Biotechnol. Adv. 1988, 6, 39–69. [Google Scholar] [CrossRef]
- Chakravorty, D.; Patra, S. Attaining Extremophiles and Extremolytes: Methodologies and Limitations. In Extremophiles; John Wiley & Sons, Inc.: Hoboken, NJ, USA, 2012; pp. 29–74. ISBN 9781118103005. [Google Scholar]
- Margaryan, A.; Shahinyan, G.; Hovhannisyan, P.; Panosyan, H.; Birkeland, N.-K.; Trchounian, A. Geobacillus and Anoxybacillus spp. from Terrestrial Geothermal Springs Worldwide: Diversity and Biotechnological Applications; Springer: Singapore, 2018; pp. 119–166. [Google Scholar]
- Thebti, W.; Riahi, Y.; Belhadj, O. Purification and Characterization of a New Thermostable, Haloalkaline, Solvent Stable, and Detergent Compatible Serine Protease from Geobacillus toebii Strain LBT 77. BioMed Res. Int. 2016, 2016, 1–8. [Google Scholar] [CrossRef]
- Khusro, A. One Factor at A Time based optimization of protease from poultry associated Bacillus licheniformis. J. Appl. Pharm. Sci. 2016, 088–095. [Google Scholar] [CrossRef]
- Vonothini, G.; Murugan, M.; Sivakumar, K.; Sudha, S. Optimization of protease production by an Actinomycete Strain, PS-18A isolated from an estuarine shrimp pond. Afr. J. Biotechnol. 2008. [Google Scholar]
- Derekova, A.; Mandeva, R.; Kambourova, M. Phylogenetic diversity of thermophilic carbohydrate degrading bacilli from Bulgarian hot springs. World J. Microbiol. Biotechnol. 2008, 24, 1697–1702. [Google Scholar] [CrossRef]
- Frankena, J.; van Verseveld, H.W.; Stouthamer, A.H. A continuous culture study of the bioenergetic aspects of growth and production of exocellular protease in Bacillus licheniformis. Appl. Microbiol. Biotechnol. 1985, 22, 169–176. [Google Scholar] [CrossRef]
- Kole, M.M.; Draper, I.; Gerson, D.F. Production of protease by bacillus subtilis using simultaneous control of glucose and ammonium concentrations. J. Chem. Technol. Biotechnol. 2007, 41, 197–206. [Google Scholar] [CrossRef]
- Bhunia, B.; Basak, B.; Dey, A. A review on production of serine alkaline protease by Bacillus spp. J. Biochem. Technol. 2012, 3, 448–457. [Google Scholar]
- Malathi, S.; Chakraborty, R. Production of Alkaline Protease by a New Aspergillus flavus Isolate under Solid-Substrate Fermentation Conditions for Use as a Depilation Agent. Appl. Environ. Microbiol. 1991, 57, 712–716. [Google Scholar] [CrossRef] [PubMed]
- Tsuchiya, K.; Sakashita, H.; Nakamura, Y.; Kimura, T. Production of Thermostable Alkaline Protease by Alkalophilic Thermoactinomyces sp. HS682. Agric. Biol. Chem. 1991, 55, 3125–3127. [Google Scholar] [CrossRef]
- Phadatare, S.U.; Deshpande, V.V.; Srinivasan, M.C. High activity alkaline protease from Conidiobolus coronatus (NCL 86.8.20): Enzyme production and compatibility with commercial detergents. Enzym. Microb. Technol. 1993, 15, 72–76. [Google Scholar] [CrossRef]
- Yang, S.-H.; Cho, J.-K.; Lee, S.-Y.; Abanto, O.D.; Kim, S.-K.; Ghosh, C.; Lim, J.-S.; Hwang, S.-G. Isolation and Characterization of Novel Denitrifying Bacterium Geobacillus sp. SG-01 Strain from Wood Chips Composted with Swine Manure. Asian-Australas. J. Anim. Sci. 2013, 26, 1651–1658. [Google Scholar] [CrossRef] [PubMed][Green Version]
- Çelik, S.Y.; Demir, N.; Demir, Y.; Adiguzel, A.; Gulluce, M. Production of pectin lyase from Geobacillus pallidus p26, purification, characterization and fruit juice application. Acta Chim. Slovaca 2014, 7, 57–63. [Google Scholar] [CrossRef]
- Kalwasińska, A.; Jankiewicz, U.; Felföldi, T.; Burkowska-But, A.; Swiontek Brzezinska, M. Alkaline and Halophilic Protease Production by Bacillus luteus H11 and its Potential Industrial Applications. Food Technol. Biotechnol. 2018, 56. [Google Scholar] [CrossRef] [PubMed]
- Van den Burg, B. Extremophiles as a source for novel enzymes. Curr. Opin. Microbiol. 2003, 6, 213–218. [Google Scholar] [CrossRef]
- Sharma, K.M.; Kumar, R.; Panwar, S.; Kumar, A. Microbial alkaline proteases: Optimization of production parameters and their properties. J. Genet. Eng. Biotechnol. 2017, 15, 115–126. [Google Scholar] [CrossRef] [PubMed]
- Hidayat, M.Y.; Saud, H.M.; Samsudin, A.A. Isolation and Characterisation of Sulphur Oxidizing Bacteria Isolated from Hot Spring in Malaysia for Biological Deodorisation of Hydrogen Sulphide in Chicken Manure. Media Peternak. 2017, 40, 178–187. [Google Scholar] [CrossRef]
- Prakasham, R.S.; Rao, C.S.; Sarma, P.N. Green gram husk—An inexpensive substrate for alkaline protease production by Bacillus sp. in solid-state fermentation. Bioresour. Technol. 2006, 97, 1449–1454. [Google Scholar] [CrossRef]
- Sattar Qureshi, A.; Aqeel Bhutto, M.; Khushk, I.; Umar Dahot, M. Optimization of cultural conditions for protease production by Bacillus subtilis EFRL 01. Afr. J. Biotechnol. 2011. [Google Scholar]
Sample Availability: Samples of the compounds are available from the authors. |

| Isolate | Zone of Hydrolytic Halo (cm) | Activity (U/mL) |
|---|---|---|
| F1 | 3.0 | 148 |
| F2 | 3.0 | 160 |
| F3 | 3.5 | 150 |
| F4 a | 3.5 | 175 |
| C1 | 3.0 | 145 |
| C2 | 3.3 | 145 |
| C3 | 3.1 | 140 |
| C4 | 3.0 | 141 |
| C5 | 3.2 | 100 |
| C6 | 2.0 | 80 |
| D2 | 2.8 | 75 |
| L8 | 3.0 | 81 |
© 2020 by the authors. Licensee MDPI, Basel, Switzerland. This article is an open access article distributed under the terms and conditions of the Creative Commons Attribution (CC BY) license (http://creativecommons.org/licenses/by/4.0/).
Share and Cite
Suleiman, A.D.; Abdul Rahman, N.; Mohd Yusof, H.; Mohd Shariff, F.; Yasid, N.A. Effect of Cultural Conditions on Protease Production by a Thermophilic Geobacillus thermoglucosidasius SKF4 Isolated from Sungai Klah Hot Spring Park, Malaysia. Molecules 2020, 25, 2609. https://doi.org/10.3390/molecules25112609
Suleiman AD, Abdul Rahman N, Mohd Yusof H, Mohd Shariff F, Yasid NA. Effect of Cultural Conditions on Protease Production by a Thermophilic Geobacillus thermoglucosidasius SKF4 Isolated from Sungai Klah Hot Spring Park, Malaysia. Molecules. 2020; 25(11):2609. https://doi.org/10.3390/molecules25112609
Chicago/Turabian StyleSuleiman, Allison D., Nor’Aini Abdul Rahman, Hidayat Mohd Yusof, Fairolniza Mohd Shariff, and Nur Adeela Yasid. 2020. "Effect of Cultural Conditions on Protease Production by a Thermophilic Geobacillus thermoglucosidasius SKF4 Isolated from Sungai Klah Hot Spring Park, Malaysia" Molecules 25, no. 11: 2609. https://doi.org/10.3390/molecules25112609
APA StyleSuleiman, A. D., Abdul Rahman, N., Mohd Yusof, H., Mohd Shariff, F., & Yasid, N. A. (2020). Effect of Cultural Conditions on Protease Production by a Thermophilic Geobacillus thermoglucosidasius SKF4 Isolated from Sungai Klah Hot Spring Park, Malaysia. Molecules, 25(11), 2609. https://doi.org/10.3390/molecules25112609

